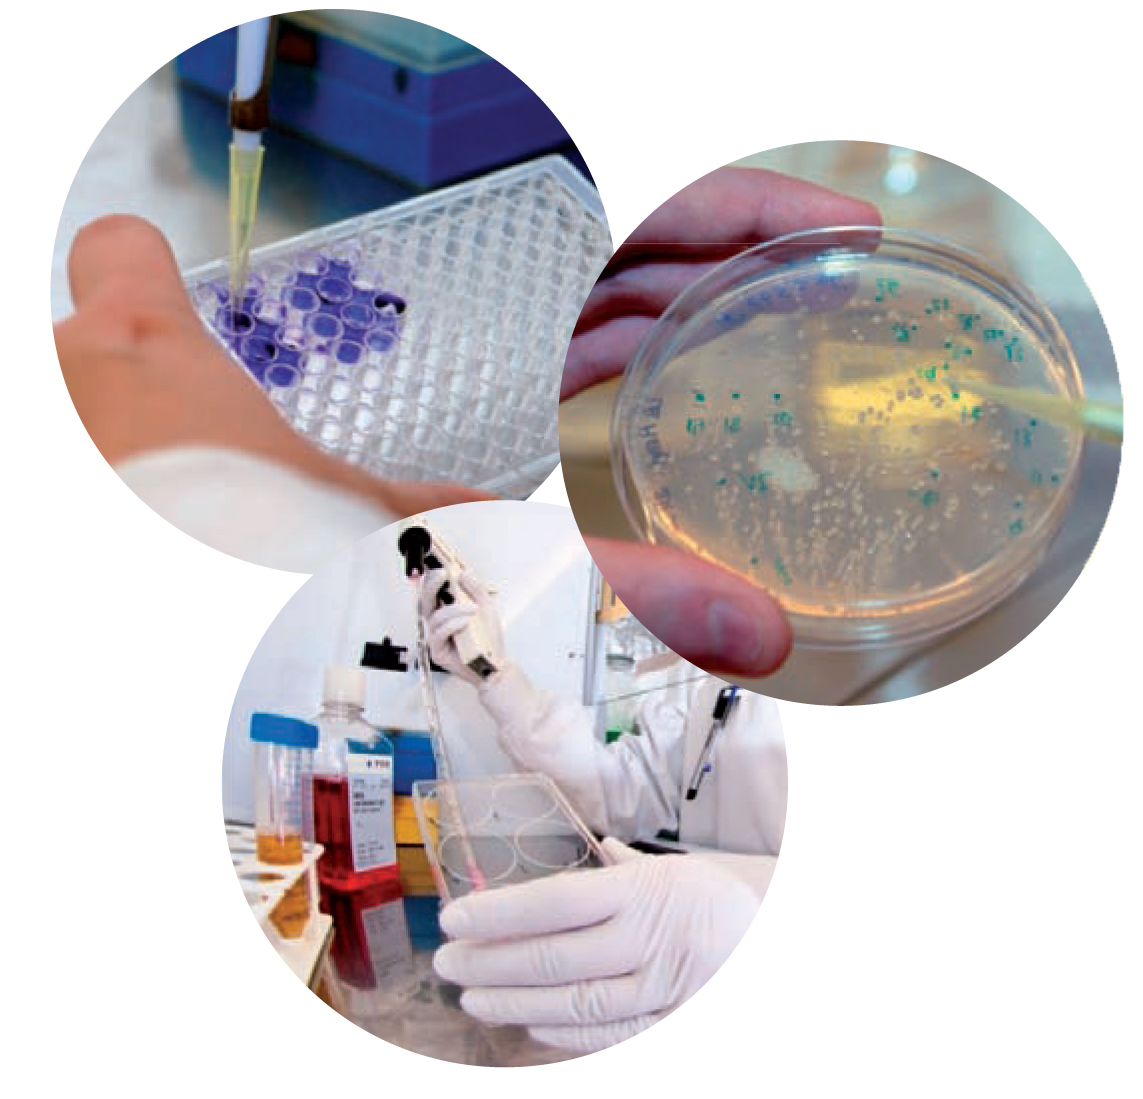
Master Signalisation cellulaire et mol&eacute;culaire

IMPORTANT
Les étudiants postulant au M2 SCM doivent obligatoirement préciser dans leur dossier de candidature le laboratoire d'accueil où ils choisissent de réaliser leur stage ainsi que le sujet de recherche sur lequel ils travailleront. Il est donc vivement conseillé de prendre contact avec les équipes de recherche avant de déposer le sujet de candidature (les adresses emails et n° de téléphone des encadrants sont indiquées dans le présent document).
UFR Sciences et techniques
16, route de Gray
25030 Besançon cedex
CS 11809
tél : 03 81 66 66 50
fax : 03 81 66 66 10
scolarite.ufr-
Régis Delage-Mourroux
tél : 03 81 66 66 24
fax : 03 81 66 62 67
regis.delage-
1ère année : enseignements à Besançon (25)
2ème année : enseignements à Besançon (25) et Dijon (21)
Ce master est également ouvert en formation continue, pour une reprise d'études (formalités administratives), contacter le service Formation continue : 03 81 66 61 21